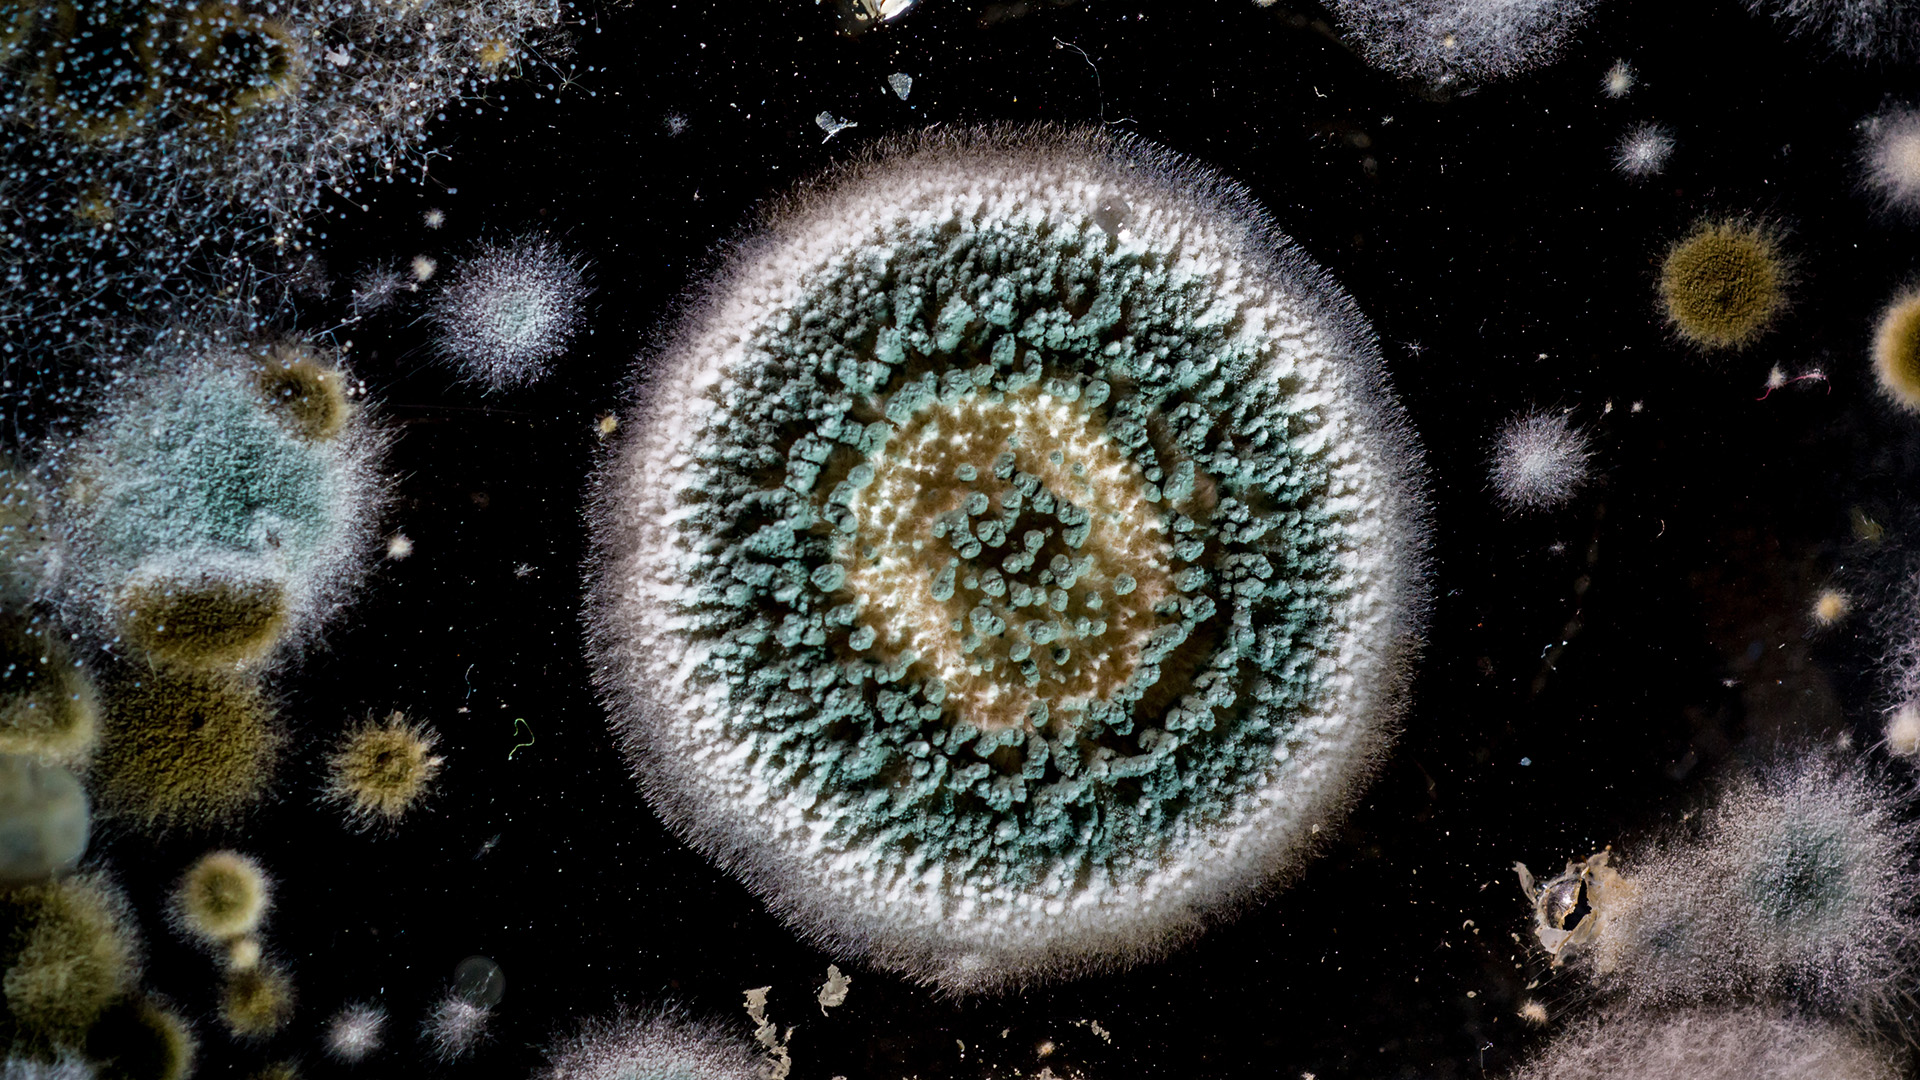
a close-up mold spore

Ever step into a room and catch a weird, damp smell that sticks in your nose? Maybe the walls feel a bit too soft in the corners, or you notice dark spots near the windows. That could be mold. And if you’ve been dealing with it, there’s a good chance you’ve asked yourself, do air purifiers help with mold, or am I just hoping too much?
I’ll tell you what mold is, how it spreads, and what an air purifier can or can’t do. I’ll also share how to stop mold early. If your home smells musty or makes you sneeze, this is for you.
Table of Contents
- Why Mold Is a Problem
- Do Air Purifiers Help Remove Mold?
- Choosing the Right Air Purifier for Mold
- Practical Tips to Prevent Mold at Home
- The Final Thought
Why Mold Is a Problem
Mold isn’t just an ugly spot on your wall. It can mess with your health. It causes allergy flare-ups, breathing trouble, and even skin irritation. Some folks feel tired all the time and never guess the real reason is in the air.
Now, here’s where it gets serious. According to the CDC, mold can trigger coughing, a stuffy nose, sore throat, or worse, if you already have asthma or allergies. Some people break out in rashes. It’s sneaky and stubborn.
High humidity is a significant contributor to the problem. Anything over 50% in your home is like a welcome sign for mold. Add poor ventilation and leaks that don’t get fixed, and you’ve got the perfect recipe.
So, even if you clean the bathroom walls, mold might still float around in the air, and that’s where air purifiers enter the picture.
Do Air Purifiers Help Remove Mold?
Here’s the deal. Air purifiers don’t wipe mold off your walls. But they do catch mold spores that move through the air. And that’s huge if you’re trying to stop it from spreading or breathing it in.
A proper air purifier features a HEPA filter. That’s not just marketing fluff. A good purifier? Yes, it can capture 99.97% of the debris floating in the air. That includes mold spores, which are super tiny. Most of them are between 1 and 30 microns, but a HEPA filter? It grabs stuff as small as 0.3. Pretty wild, right?

Now, here’s the sweet part—if your purifier also has carbon in it, it can soak up that weird, musty smell that mold leaves behind. You know the one. The room starts to feel fresher. And yeah, it smells way nicer, too.
But let’s be real. A purifier isn’t magic. It won’t fix your leaky sink or dry out your damp walls. It won’t chase mold off your ceiling. You still gotta deal with the wet spots and clean things up. What it can do is help the air feel lighter and cleaner. Less stuff is going into your lungs. That matters.
Oh, and one more thing—don’t forget the floor. Spores don’t just hang in the air. They fall mixed with dust and pet hair. That’s why having a robot vacuum like Dreame’s can make a big difference. It cleans while you chill.
Choosing the Right Air Purifier for Mold
Not all air purifiers do the same job. If you want one that really helps with mold, look for a few key things:
- • HEPA filter – This is a must. It traps mold spores and keeps them from floating around.
- • High CADR – That stands for Clean Air Delivery Rate. Higher means faster air cleaning.
- • Room size match – Get one that fits the space. If your basement is 300 square feet, make sure the purifier covers that much.
- • Carbon filter – Helps knock out that musty, moldy smell.
- • Smart placement – Put it near mold-prone spots. Close to the bathroom, laundry room, or anywhere that stays damp.
Now, here’s a solid option if you’re not sure where to start. The Dreame AirPurSue PM20 doesn’t play around. It was tested in a lab and proved to remove 99.9% of black mold spores (Aspergillus niger) in just 1 hour.
How? The filter doesn’t just trap stuff; it attracts it. The system uses a combo of tight fiber layers and electrostatic charge. So mold spores get stuck and stay stuck. No floating back into the room. This helps a lot for people with allergies, young children, or those who dislike dirty air.
This purifier also works well in wet places like basements or bathrooms. If you live somewhere rainy or muggy, it’s a smart addition.
Practical Tips to Prevent Mold at Home
Want to beat mold for good? Don’t just rely on the air purifier. Try a few of these tips too:
- • Fix leaks fast. Don’t wait days.
- • Use fans in bathrooms and kitchens.
- • Dry any wet spots within 2 days.
- • Store things in dry, clean places.
- • Don’t hang wet clothes indoors.
- • Use mold-resistant paint in damp rooms.
The Final Thought
So, do air purifiers help with mold? Yes, but with limits. They won’t scrub your walls or dry your leaky pipes, but they do cut down the mold spores floating in your air. That means cleaner lungs, fewer smells, and a better shot at keeping mold from spreading.
Just remember: for real results, mix things up. Use the purifier, fix the leaks, keep things dry, and clean the air and surfaces. When you combine everything, you take away what mold needs to grow.
If you’re serious about your air, the Dreame AirPurSue Series is worth looking into. And if you want to go even further, Dreame’s robot vacuums can help keep your floors clean, which also keeps mold spores from building up.
Cleaner air means fewer problems. Your home deserves that, and so do you.
References